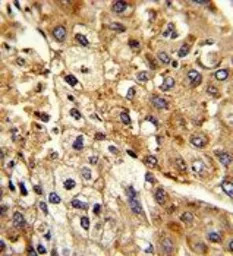
Sodium/Potassium ATPase beta 2

相关产品推荐更多 >
万千商家帮你免费找货
0 人在求购买到急需产品
- 详细信息
- 文献和实验
- 技术资料
- 免疫原:
KLH conjugated synthetic peptide between 115-141 amino acids from the Central region of human ATP1B2.
- 亚型:
IgG
- 形态:
Liquid
- 保存条件:
Store as concentrated solution. Centrifuge briefly prior to opening vial. For short-term storage (1-2 weeks), store at 4ºC. For long-term storage, aliquot and store at -20ºC or below. Avoid multiple freeze-thaw cycles.
- 克隆性:
Polyclonal
- 标记物:
Unconjugated
- 适应物种:
Human, Rat
- 保质期:
12 months from the shipping date of the product.
- 抗原来源:
Human
- 目录编号:
GTX80450
- 级别:
Primary Antibodies
- 库存:
Available
- 供应商:
GeneTex
- 宿主:
Rabbit
- 应用范围:
WB, IHC-P, FACS
- 浓度:
Batch dependent (Please refer to the vial label for the specific concentration.)
- 靶点:
Sodium/Potassium ATPase beta 2
- 抗体英文名:
Sodium/Potassium ATPase beta 2 antibody, Internal
- 抗体名:
Sodium/Potassium ATPase beta 2 抗体, Internal
- 规格:
400 μl

FACS analysis of K562 cells using GTX80450 Sodium/Potassium ATPase beta 2 antibody, Internal.
Top histogram : negative control
Bottom histogram : K562 cells
IHC-P analysis of human hepatocarcinoma using GTX80450 Sodium/Potassium ATPase beta 2 antibody, Internal.

WB analysis of K562 cells and rat liver using GTX80450 Sodium/Potassium ATPase beta 2 antibody, Internal.
Loading : 35ug per lane
Dilution : 1:1000
风险提示:丁香通仅作为第三方平台,为商家信息发布提供平台空间。用户咨询产品时请注意保护个人信息及财产安全,合理判断,谨慎选购商品,商家和用户对交易行为负责。对于医疗器械类产品,请先查证核实企业经营资质和医疗器械产品注册证情况。
 文献和实验
文献和实验secondary antibody review -- data from 99 publications
cytometry used as a control to detect cell responses targeted antigen 7 Alexa Fluor 488 7 Cy3 8 goat IgG Alexa Fluor 488 1:2000 detect antibody binding in human embryonic kidney 293T cells Invitrogen 9 donkey
Phycoerythrin conjugation protocol
and Centricon concentrators. Add 0.5% sodium azide. Store at 4 °C protected from light. Do not freeze. Figure 1. Analysis of column eluate fractions from PE conjugation of monoclonal antibody IB4 (murine IgG2a, anti-human CD
, although some hypotheseshave been suggested. The first hypothesis proposes lithium as amagnesium (Mg 2+ )-competitive inhibition of GSK-3 (16) , whereasthe second suggests lithium inhibitor by potassium deprivation (17) . Lithium is a nonspecific GSK-3 inhibitor
 技术资料
技术资料暂无技术资料 索取技术资料






![mCherry antibody [GT857]](https://img1.dxycdn.com/2022/0329/666/1828508537985020453-14.jpg!wh200)
![ATP6V1A antibody [GT811]](https://img1.dxycdn.com/2022/0329/975/0518554021537020453-14.jpg!wh200)
![p27 Kip1 antibody [3D8]](https://img1.dxycdn.com/2022/0328/410/8998014903737500453-14.jpg!wh200)
![EpCAM antibody [HL1524]](https://img1.dxycdn.com/2022/0815/524/0212727665110295653-14.jpg!wh200)

